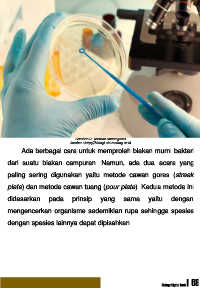

Page 73 - Biology Digital Book
P. 73
Gambar 62. Metode cawan gores
Sumber : http://biologi.uin-malang.ac.id
Ada berbagai cara untuk memproleh biakan murni bakteri
dari suatu biakan campuran. Namun, ada dua acara yang
paling sering digunakan yaitu metode cawan gores (streak
plate) dan metode cawan tuang (pour plate). Kedua metode ini
didasarkan pada prinsip yang sama yaitu dengan
mengencerkan organisme sedemikian rupa sehingga spesies
dengan spesies lainnya dapat dipisahkan.
Biology Digital Book | 68